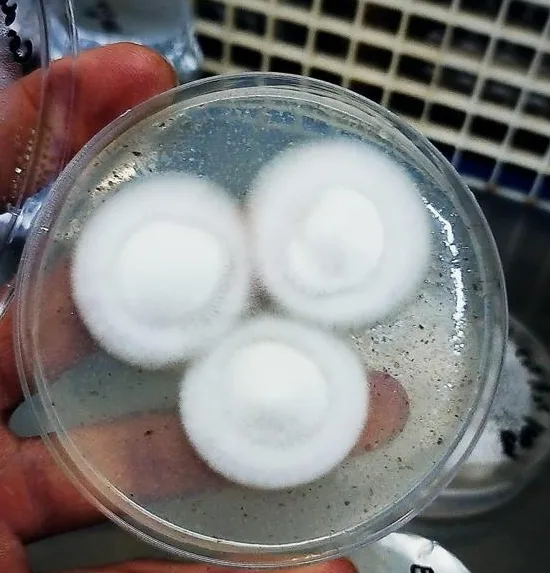
Cepas de hongos medicinales

Cepas de hongos medicinales
Cepas en micelio líquido
Para los cultivadores de hongos es fundamental contar con recursos genéticos de primera calidad a precios competitivos. Muchas veces las cepas disponibles en el mercado están deterioradas, contaminadas o no han sido testeadas en entornos de alta demanda, lo que incrementa el riesgo de un desempeño pobre. Te aconsejamos adquirir cepas resguardadas en laboratorios especializados para asegurar la máxima calidad en tu inversión.
Especificaciones
| Variedades medicinales | Ganoderma lucidum, Ganoderma curtisii, Hericium erinaceus, Trametes versicolor, Cordyceps militaris, Lentinula edodes |
| Etiquetas | |
|---|---|
| Etiquetas | |